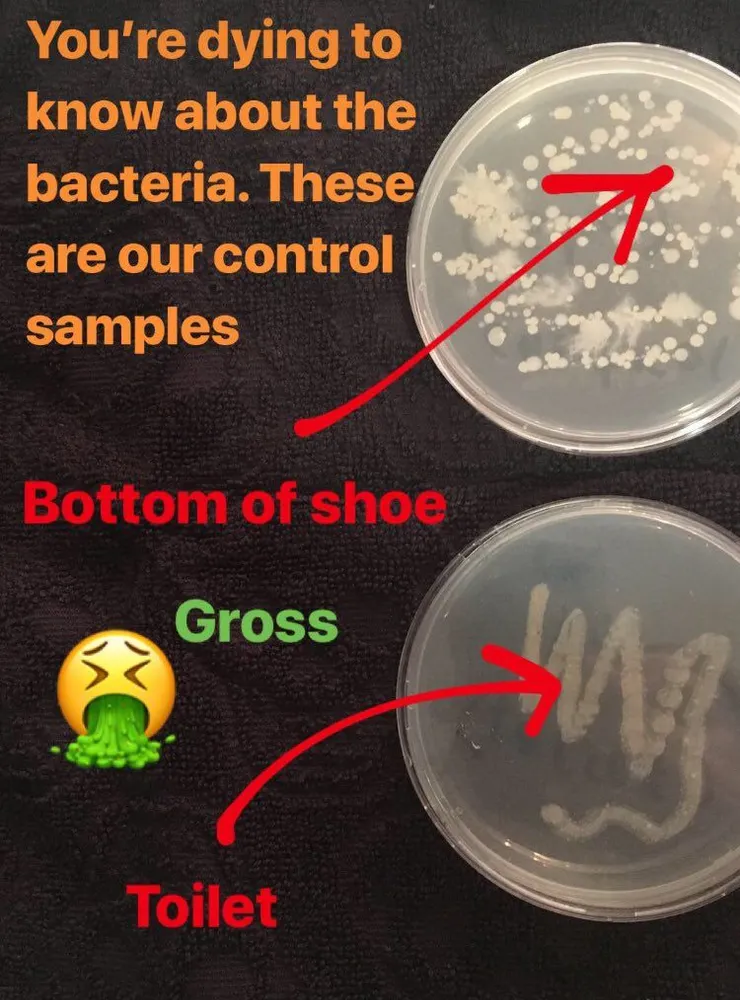
vocus｜新世代的創作平台

鞋子本身的病菌
你的鞋子,比馬桶🚽蓋更髒,馬桶蓋平均會有1000隻病菌,但鞋子🥿卻有百萬隻病菌沾黏在上面。
早在2008年,美國Arizona 大學曾經發現,我們日常生活中的「鞋子外表」,平均充滿了421,000隻病菌

這些包括了像葡萄球菌。而你的「鞋子內部」,也長滿了近3000隻病菌、這也包括了像霉菌。

你的鞋底,沾滿了糞便菌
你的鞋底,96%沾滿了糞屎的細菌。你一定很驚訝🙀?糞便?【你印象沒有採過糞呀?】其實,真的不是你想像的那樣.那樣..
這些糞屎細菌🧫包括最常見的就是大腸桿菌(E.coli)、克雷伯氏肺炎菌(Klebsiella pneumonia’s)和粘質沙雷氏菌(Serratia ficaria)

沾滿鞋底下的新冠病毒🦠⋯⋯
《新英格蘭醫學期刊》一篇研究曾指出,「新冠病毒可在鞋底存活5天」!
文章中也引述:美國聖地亞哥醫師納諾斯(Georgine Nanos)表示,若民眾經常在公共空間走動,例如:辦公室、大賣場、大眾交通運輸等地,鞋底有很大的機率會沾染新冠病毒。而坎薩斯州公衛學家溫納(Carole Winner)也表示,鞋底,通常是由塑料與其他合成材料製成,很有可能附著病毒。

看到以上,上個月很多記者在問我?真的假的?
最近又發現醫護人員的鞋底有一半都被驗出有新冠病毒,而醫院各處的地板都有病毒。研究人員認為,有機會是透過醫護人員的鞋底傳播開????

哎呀,現在正是COVID19 當道,你說空氣,玻璃,金屬製品,大家嘛都會説有偵測到COVID19 踪跡的可能性。
其實病毒 ,細菌、霉菌,什至寄生蟲,都會真的能夠沾黏在鞋底下,其實這不稀奇的。我們平常生活,鞋子病菌報告早已知道病毒 ,細菌、霉菌,寄生蟲,都真的能夠沾黏在鞋底下:
室外

我們在室外,你踩著草地,或踏過乾枯葉子,那些超標病菌,可能正快樂在‘吃東西’,被你大力踩著,就這樣沾黏到鞋底,有幸的,跟著我們的雙腳👣到處去傳播了。同樣的情況下,在室外到處也都是,一大堆鳥類,𠖥物的糞屎,乾或濕的環境例如廁所,你踩到了,【到處都會是糞屎病菌】呀!
室內

Clostridium difficile 那是一種在室內,廣泛存在的病菌之一。美國休士頓大學研究發視,其在室內環境中的樓梯地表上,竟然70%有這種細菌。他們進一步研究發現:如果【穿著涼鞋】踩過樓梯上下樓,其28%的鞋底會有這個細菌、而【穿著球鞋】者中,其43%鞋底也會有這個細菌。你想不到,你的辦公室大樓,每日有人打掃那麼乾淨,依舊有那麼多病菌呢!
鞋帶的病菌

順便提一下鞋帶的髒吧。我們剛剛在鞋子所提到的病菌,99%都會沾到鞋帶上去。那是因為《鞋帶一直搖搖晃晃,在地板上,在鞋板上打著,磨蹭著》,當然可以想像有如繩子亂晃,到處沾滿了病菌。

這些病菌包括了細菌,病毒和寄生蟲。你一定有鞋帶鬆綁,你蹲下綁鞋帶,當然你的手指頭,也可能沾了剛剛上面説的糞屎病菌喲!其實【綁完鞋帶,真的要記得馬上洗手】才對!
鞋材質的病菌
鞋子大部分由帆布,塑膠材質和皮革製品所作成的,但研究人員發現不管鞋子的材質是什麼做成的,其病菌的溫床數目,幾乎都是一樣的如下圖。

可以想像不管鞋子的材質是什麼,我們都會穿鞋子到處趴趴走、也到處沾滿了病菌。所以不要擔心穿什麼材質的鞋子出門了,先擔心自己鞋子,會有各種不同致病的細菌🧫、怎麼清洗消毒吧⋯⋯
三大方法也許可以阻絕鞋子的致病的細菌🧫吧:
A. 管理好你的鞋子
1.不要馬上入屋
到家開門後,不要馬上入屋。先在屋外踏上消毒地氈,再脫鞋。

2.屋外有鞋櫃
如果沒消毒地氈,外出的鞋子,最好放在入門前固定污染角落或格子或鞋櫃內。千萬不要把鞋子穿到屋內,即使你的視力檢查超級好,【致病的細菌🧫,不是你肉眼所能看到的。】

3.要有室內鞋
把在出外髒的鞋子,放在門外或空氣流通的地方如露台吹一晚,隔天出門再穿回去。【一定要有室內鞋,不能赤腳入客廳】。區分內外鞋,室內鞋和外出的鞋子,也是最好固定一雙 。

B.鞋子消毒和清潔

帆布、人工皮革,以及其他織物製成的鞋子,可考慮用洗衣機進行低溫清洗;皮鞋及工作鞋,可考慮用酒精進行消毒清潔。(每種不同的製成的鞋子,都有其製造商的建議。)大約的消毒和清潔原則如下 :
鞋底
可用消毒液和毛刷清潔。

鞋面
傳統皮鞋面,也可使用消毒液和毛刷清潔

鞋帶
拆卸後,浸泡和搓洗。
切忌用任何毛刷,否則會起球和拉絲

鞋帶孔
用棉花棒或牙刷進行清潔,拭乾。

C.勤洗手 預防感染王道
勤洗手,再勤洗手就對了。
門口放一小瓶75%酒精勤洗手 : 脫鞋後、穿鞋後、綁鞋帶後,方便勤洗手使用。

儘管我們發現這種病毒,仍然可以在空氣中存活幾小時,但這項新研究,不代表病毒🦠,就是可以在空氣傳播。
同樣的,儘管我們發現這種病毒,仍然可以在鞋底下,但這項新研究,也不代表病毒🦠,就是可以從鞋子傳播給人。

除非你真的【不洗手,病毒就會可能隨著你觸碰摸口鼻後,傳入你的身體內】了。
























